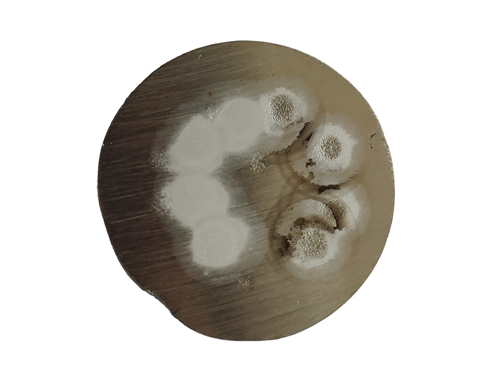

Optical emission spectrometer has been widely used in industry because of the advantages of fast analysis speed and reliable analysis results. However, fast analysis speed and reliable results are based on the effect of the excitation point. If white points appear in the excitation, we should start from which Aspects to solve:
1. Insufficient argon flushing time: if the purity of argon in the excitation chamber is not direct enough, the excitation point will be white.
2. Whether the argon gas exhaust is smooth: If the argon gas path is not smooth, it will cause insufficient gas to reach the gas chamber, so it is difficult to excite the good sample.
3. Whether the sample has trachoma or cracks: Regardless of the standard sample or the homemade sample, if there are trachoma or cracks on the surface of the sample, it will directly lead to the excitation of white spots.
4. Samples with relatively high C and Si elements, such as gray iron or ductile cast iron, need to be whitened. If they are not or not handled properly, they will directly lead to white spots when excited, and can not obtain accurate values.
5. The surface treatment effect of the sample is not good: the surface needs to be ground flat after preparation. If it is not ground, direct excitation will lead to poor sealing of the excitation gas chamber, resulting in poor excitation effect and white spots.
6. The purity of argon gas is not enough: the spectrometer has special requirements for the purity of argon gas. If the high-purity argon gas purchased on the market is not handled properly during filling, it will directly cause the purity of argon gas in the argon gas bottle to be insufficient. Argon does not mean that the purity of each bottle is sufficient for spectrometer use, unless an argon purifier is available.